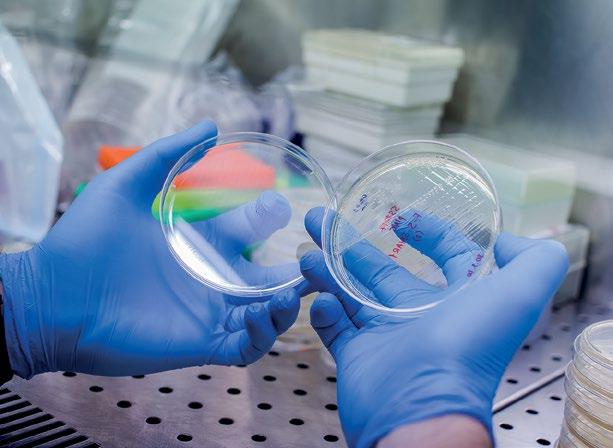

# 072

Think

6
10
23
24
28
30
32
34








50
54
56
58
66
72
www.virus.com.gr • www.phb.com.gr • www.ethosmedia.eu • www.ethosevents.eu • www.banks.com.gr • www.insuranceworld.gr
ISSN: 2241-0961


Λόγω της μείωσης της δημόσιας εξωνοσοκομειακής
χρηματοδότησης κατά περίπου 31%, αυξήθηκε η συμμετοχή της βιομηχανίας κατά 386%.

θεραπεία υποτροπιάζουσας ή ανθεκτι-
νόσου σε ασθενείς με Non-Hodgkin
λέμφωμα (NHL) από Β-κύτταρα, οξεία Β-
λεμφοβλαστική λευχαιμία (Β-ΟΛΛ) και
Πολλαπλό Μυέλωμα (ΠΜ).
Συγκεκριμένα, το διάχυτο από μεγάλα Β-
κύτταρα λέμφωμα αποτελεί τον συχνότε-
ρο ιστολογικό τύπο NHL στον Δυτικό Κό-
σμο. Παρά την ύπαρξη αποτελεσματικών
φαρμάκων, η αστοχία στη συμβατική θε-
ραπεία επισυμβαίνει περίπου στο
Yescarta
Gilead, Kymriah
Tecartus
Novartis και
Breyanzi της BMS.




Το gemtuzumab ozogamycin






GO (40,8%
17,1%) και
συνολικής επιβίωσης (53,2% έναντι 41,9%) στα 2 έτη.






σε ασθενείς στους οποίους έχουν αποτύχει άλλες θεραπείες.
της πρωτεΐνης BCL2. Οι σημαντικότερες εξελίξεις στη
νεότερων ανοσοθεραπει-
Αυτές περιλαμβάνουν τις

HAlbert Bourla, PhD,
Pfizer,
Robert Bradway
Eli Lilly
Amgen,
David Ricks
ο Daniel O’Day
Gilead Sciences,
Clay Siegall
